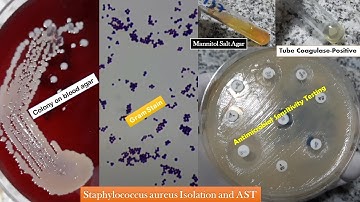
Staphylococcus aureus golden yellow colonies, Gram stain, Coagulase test, Growth on MSA and AST

⬇ DOWNLOAD NOW
Kalau muncul iklan pop-up, tutup lalu klik tombol kembali
Download lagu Staphylococcus aureus (Microscopic morphology and Cultural Characteristics), Part 2 secara gratis hanya untuk keperluan promosi. Dukung artis favorit kamu dengan membeli musik original di iTunes atau platform resmi lainnya.
 Staphylococcus aureus
Staphylococcus aureus
 Staphylococcus aureus (Microscopic morphology & Cultural Characteristics)
Staphylococcus aureus (Microscopic morphology & Cultural Characteristics)
 Staphylococcus aureus (Microscopic morphology and Cultural Characteristics), Part 1
Staphylococcus aureus (Microscopic morphology and Cultural Characteristics), Part 1
 Staphylococcus Aureus Growth & Colony Morphology
Staphylococcus Aureus Growth & Colony Morphology
 Cultural Characteristics Of Staphylococcus aureus @EnteMicrobialWorld #microbiology #bacteria #vbs
Cultural Characteristics Of Staphylococcus aureus @EnteMicrobialWorld #microbiology #bacteria #vbs
 Staphylococcus aureus | complete overview | microbiology
Staphylococcus aureus | complete overview | microbiology
Staphylococcus aureus golden yellow colonies, Gram stain, Coagulase test, Growth on MSA and AST
Staphylococcus aureus golden yellow colonies, Gram stain, Coagulase test, Growth on MSA and AST
 Staphylococcus aureus Explained (Microbiology ASMR)
Staphylococcus aureus Explained (Microbiology ASMR)